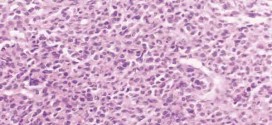

El síndrome bulbar. Conjunto de síndromes caracterizados por diversos trastornos que afectan y controla actos automáticos como la tos, el vómito, el estornudo y la deglución, los nervios motores de la lengua, de la boca y de la cara, con alteraciones en la deglución y fonación. En función del nervio afectado se distinguen los síndromes bulbares anterior, lateral posterior y …
Leer MásS
SARCOMA DE LA VESÍCULA BILIAR
El sarcoma de la vesícula biliar. Es una enfermedad por la cual se forman células malignas cancerosas en los tejidos de la vesícula biliar es una enfermedad poco frecuente por la que se encuentran células cancerosas en los tejidos de la vesícula biliar. Tumor maligno en general y especialmente el formado por células epiteliales, a saber. Los canceres se dividen …
Leer MásSÍNDROME DE BROWN-SEQUARD
El síndrome de brown-sequard. Síndrome ocasionado por la sección de la mitad de la médula espinal; se caracteriza por una hemiplejía y hemianestesia térmica, dolorosa y táctil en el lado opuestos. Produce parálisis en un lado y anestesia en el otro. Para todas estas patologías la madre naturaleza nos regala sus dones más preciados para nuestra salud y recuperación y …
Leer MásSÍNDROME DE BERNARD-HORNER
El síndrome de bernard-horner. Síndrome provocado por un proceso patológico de las fibras nerviosas del sistema simpático cervical a causa de un tumor, alteración vascular, compresión, etc., que se caracteriza por una ptosis (caída del párpado), una miosis (contracción de la pupila) y una enoftalmia (aparente hundimiento del globo ocular); también puede ir acompañado de una vasodilatación y ausencia de …
Leer MásSÍNDROME CEREBELOSO
El síndrome cerebeloso. Conjunto de trastornos nerviosos debidos a la lesión del cerebelo y que se manifiestan por una incapacidad de permanecer en pie sin oscilar o de andar sin perder el equilibrio. Trastornos de la dirección matriz, dismetría, trastornos del lenguaje, incoordinación, asinergia, etc. El paciente aumenta la base de sustentación marchando con las piernas muy separadas, no tiene …
Leer MásSÍNDROME DE PANCOAST
El síndrome de pancoast. Tumor maligno en general y especialmente el formado por células epiteliales. Durante los primeros años de vida de una persona, las células normales se dividen más rápidamente para permitir el crecimiento. El cuerpo está compuesto por billones de células vivas. Las células normales del cuerpo crecen, se dividen formando nuevas células y mueren de manera …
Leer MásSÍNDROME DE SWEET
El síndrome de sweet. Tumor maligno ó manchas malignas en general y especialmente el formado por células epiteliales o pigmentarias. Los canceres se dividen en dos grandes categorías de carcinoma y sarcoma. La característica básica de la malignidad es una anormalidad de las células, trasmitida a las células hijas, a saber, que se manifiesta por la reducción del control del …
Leer MásSÍNDROME DE ZOLLINGER-ELLISON
El síndrome de zollinger-ellison. Tumor maligno en general y especialmente el formado por células epiteliales. Los cánceres se dividen en dos grandes categorías de carcinoma y sarcoma, a saber. La característica básica de la malignidad es una anormalidad de las células, a saber, transmitidas a las células hijas, a saber, que se manifiestan por la reducción del control del crecimiento …
Leer MásSIGNO DE BABINSKI
El signo de babinski. Extensión del dedo gordo, y accesoriamente de los demás dedos. Reflejo cutáneo anormal de la planta del pie en el que el dedo gordo en lugar de flexionarse al ser rascado, se extiende; suele ir acompañado de una flexión de la rodilla y la cadera. Se relaciona con una lesión de la vía piramidal del sistema …
Leer MásSÍNDROME DE GORLIN
El síndrome de gorlin. Tumor maligno ó manchas malignas en general y especialmente el formado por células epiteliales o pigmentarias. Los canceres se dividen en dos grandes categorías de carcinoma y sarcoma. La característica básica de la malignidad es una anormalidad de las células, trasmitida a las células hijas, a saber, que se manifiesta por la reducción del control del …
Leer MásSÍNDROME DE LYELL
El síndrome de Lyell. También llamado (necrólisis epidérmica tóxica, síndrome de piel escaldada, epidermólisis bullosa). Un síndrome bastante poco frecuente caracterizado por una severa erupción ampollosa de la piel y de las membranas mucosas con fiebre, malestar, conjuntivitis y eritema difuso. La recuperación es lenta y pueden formarse contracturas de la piel. A menudo es letal entre los niños y …
Leer MásSARCOMA DE EWING
El sarcoma de ewing. Constituye el 10-15% de los sarcomas óseos. Tiene predilección por las diáfisis de los huesos largos y por los planos. El tumor consta de láminas de células pequeñas y redondas, que se tiñen de azul. Este tumor es miembro de una familia denominada tumores neuroectodérmicos primitivos periféricos (PNET). Suele extenderse a los pulmones, médula ósea y …
Leer MásSINUSITIS
La sinusitis es la inflamación de la mucosa de un seno, de la cara especialmente. Favorecen la sinusitis la obstrucción de los orificios de la nariz del complejo etmoidal anterior y del meato medio por secreciones retenidas, edema de la mucosa. También pueden desencadenar la infección los traumatismos y los defectos del transporte ciliar. El sondaje nasal durante más de …
Leer MásSÍNDROME DEL INTESTINO IRRITABLE (SII)
El síndrome del intestino irritable (SII). También se le suele denominar aunque puedan ser incompletas: colon irritable, síndrome de colon irritable (SCI), colitis mucosa, colon espástico, colitis nerviosa, colon espasmódico, colitis espástica, colitis mucosa neurogénica, colon inestable, colon nervioso, etc. Cuya denominación exacta, no es lo más importante de esta patología, si no la esperanza de mejorar o mejor radicarla. …
Leer MásSÍNDROME DE RESISTENCIA A LA INSULINA
El síndrome de resistencia a la insulina. La causa se desconoce o no se conoce perfectamente, a saber. Su fisiopatología es extremadamente compleja y solo ha sido dilucidada algunas partes de ella. Resumiendo: La mayoría de estos enfermos tienen una edad algo mayor, son obesos, sedentarios, hipertensión, colesterol y tienen cierto grado de resistencia a la insulina. La resistencia a …
Leer MásSIDA-VIH
El sida o el VIH, también con otros nombres como: VHI, virus de las inmunodeficiencia humana, síndrome de inmunodeficiencia adquirida, LAV/HTLV III, HIV. Retrovirus de la familia retroviridae, que afecta principalmente los linfocitos T CD4+ (célula sanguínea mononucleada originada en la médula ósea, que se encuentra en la sangre y en los órganos linfoides (ganglios linfáticos, bazo, timo) que interviene …
Leer MásADENOCARCINOMA DE GLÁNDULAS SALIVARES MENORES
El adenocarcinoma de glándulas salivares menores. Durante los primeros años de vida de una persona, las células normales se dividen más rápidamente para permitir el crecimiento. El cuerpo está compuesto por billones de células vivas. Las células normales del cuerpo crecen, se dividen formando nuevas células y mueren de manera ordenada. Una vez que se llega a la edad adulta, …
Leer Más Binipatia e higienismo Medicina natural alternativa, plantas medicinales y remedios caseros naturales
Binipatia e higienismo Medicina natural alternativa, plantas medicinales y remedios caseros naturales